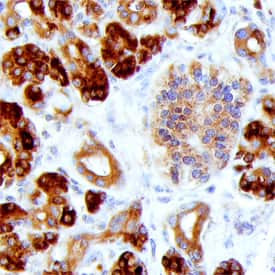
REG1A/REG1B Antibody in Immunohistochemistry (Paraffin) (IHC (P))

Search
Invitrogen
REG1A/REG1B Monoclonal Antibody (431211)
{{$productOrderCtrl.translations['antibody.pdp.commerceCard.promotion.promotions']}}
{{$productOrderCtrl.translations['antibody.pdp.commerceCard.promotion.viewpromo']}}
{{$productOrderCtrl.translations['antibody.pdp.commerceCard.promotion.promocode']}}: {{promo.promoCode}} {{promo.promoTitle}} {{promo.promoDescription}}. {{$productOrderCtrl.translations['antibody.pdp.commerceCard.promotion.learnmore']}}

Please note: We are reviewing Western blot images included in the antibody testing data in our catalog, including those provided by third parties. Unless expressly labeled or annotated as “raw-unedited”, Western blot images included in the antibody testing data in our catalog may have been edited, optimized or otherwise adjusted for presentation.
产品信息
MA5-61501
种属反应
宿主/亚型
分类
类型
克隆号
抗原
偶联物
形式
浓度
规格
纯化类型
保存液
内含物
保存条件
运输条件
RRID
产品详细信息
Reconstitute with sterile PBS to a final concentration of 0.5 mg/mL.
靶标信息
REG1A (Regenerating Islet-Derived 1 Alpha) and REG1B (Regenerating Islet-Derived 1 Beta) are genes that encode proteins belonging to the regenerating gene (REG) family, which are involved in tissue regeneration, cell proliferation, and differentiation. These proteins are predominantly expressed in the pancreas and play a significant role in the regeneration of pancreatic islet cells, which are crucial for insulin production. REG1A and REG1B are also involved in the maintenance and repair of the gastrointestinal tract lining. Elevated levels of REG proteins have been observed in conditions such as diabetes, pancreatitis, and certain gastrointestinal diseases, indicating their importance in disease pathology and potential as biomarkers. Additionally, these proteins may have roles in tumorigenesis, as their expression is often upregulated in various cancers, including pancreatic and colorectal cancers. Understanding the regulation and function of REG1A and REG1B is essential for developing therapeutic strategies aimed at enhancing tissue regeneration and treating related diseases. Their involvement in cell growth and repair processes makes them promising targets for research in regenerative medicine and oncology.
仅用于科研。不用于诊断过程。未经明确授权不得转售。